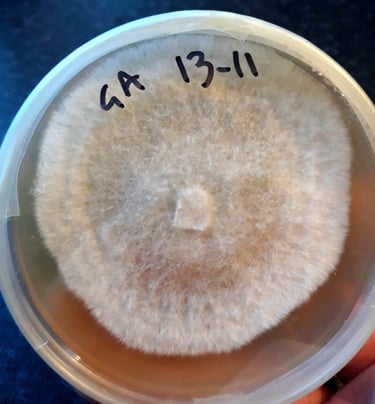
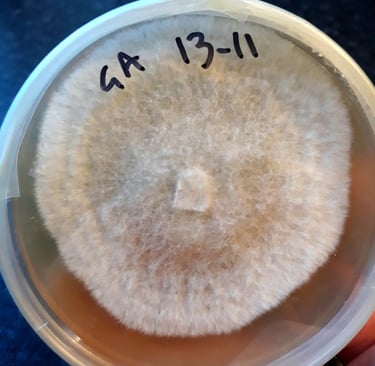

Projects
I create sculpture and installations that explore the entanglements, baffling complexity and weirdness that exists in nature. I blend biology, science fiction and fantasy to create new narratives that involve collaboration with living organisms to create stories about their lives, whether real or imagined.